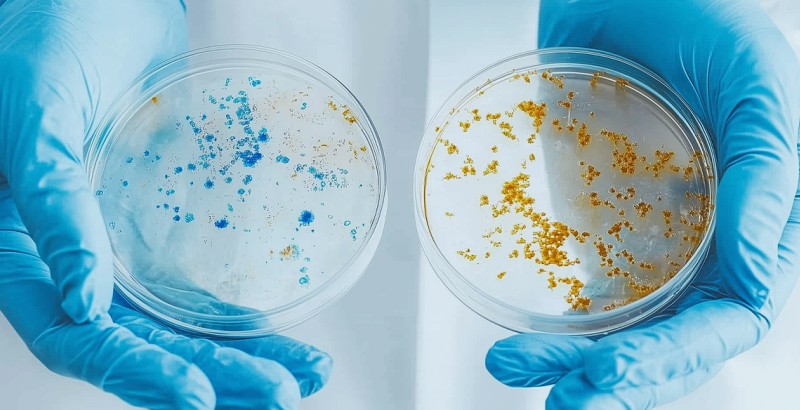

Institut Dr. Nuss Joins CERTANIA Group
The expert in chemical and microbiological environmental analysis joins the group.
Bad Kissingen/Munich, September 25, 2024 – Institut Dr. Nuss, a leading expert in chemical and microbiological analysis, is proud to announce its integration into CERTANIA, a dynamic group specializing in Testing, Inspection, and Certification services. This strategic integration marks a significant milestone for Institut Dr. Nuss, strengthening its capacity to deliver comprehensive solutions across the diverse sectors of environmental examination and consultation.
Founded in 1976 and headquartered in Bad Kissingen, Franconia, Germany, Institut Dr. Nuss has established itself as a premier provider of environmental analysis. The institute employs the latest technology in their laboratories to analyze a wide variety of matrices for environmental and health-related contaminants and ingredients. Along with a diversified clientele, including medium-sized European companies, public institutions, and private individuals, the institute ensures operational stability and long-term growth.
By joining CERTANIA, Institut Dr. Nuss gains access to a robust platform that will enable it to further expand its service offerings, particularly in the growing Food & Environment sector. The partnership will enhance the institute's ability to address increasing demand for environmental analysis driven by stringent European regulations such as the Drinking Water Directive.
Founder Dr. Elke Nuss hands over her managing directorship to the long-time trusted employee Dr. Thomas Stahl, ensuring continuity in the institute's mission to provide high-quality and reliable services. Under the leadership of the new CEO, the institute will benefit from CERTANIA’s resources and expertise. "We are excited to join CERTANIA, a group that shares our commitment to excellence in environmental analysis" said Dr. Elke Nuss. "This partnership will allow us to leverage CERTANIA’s vast resources and industry knowledge, enabling us to continue delivering top-tier solutions to our clients."
Moritz Gruber, CEO and managing shareholder of CERTANIA, welcomed Institut Dr. Nuss to the group, emphasizing the strategic importance of the acquisition. "The addition of Institut Dr. Nuss significantly strengthens CERTANIA’s position in the Food & Environment market. Their expertise in chemical and microbiological analysis perfectly complements our existing services, and we see tremendous potential for synergy and growth." CERTANIA’s acquisition of Institut Dr. Nuss underscores the group’s commitment to expanding its capabilities in the environmental analysis sector, enhancing its market presence in Germany and beyond. The integration is expected to drive